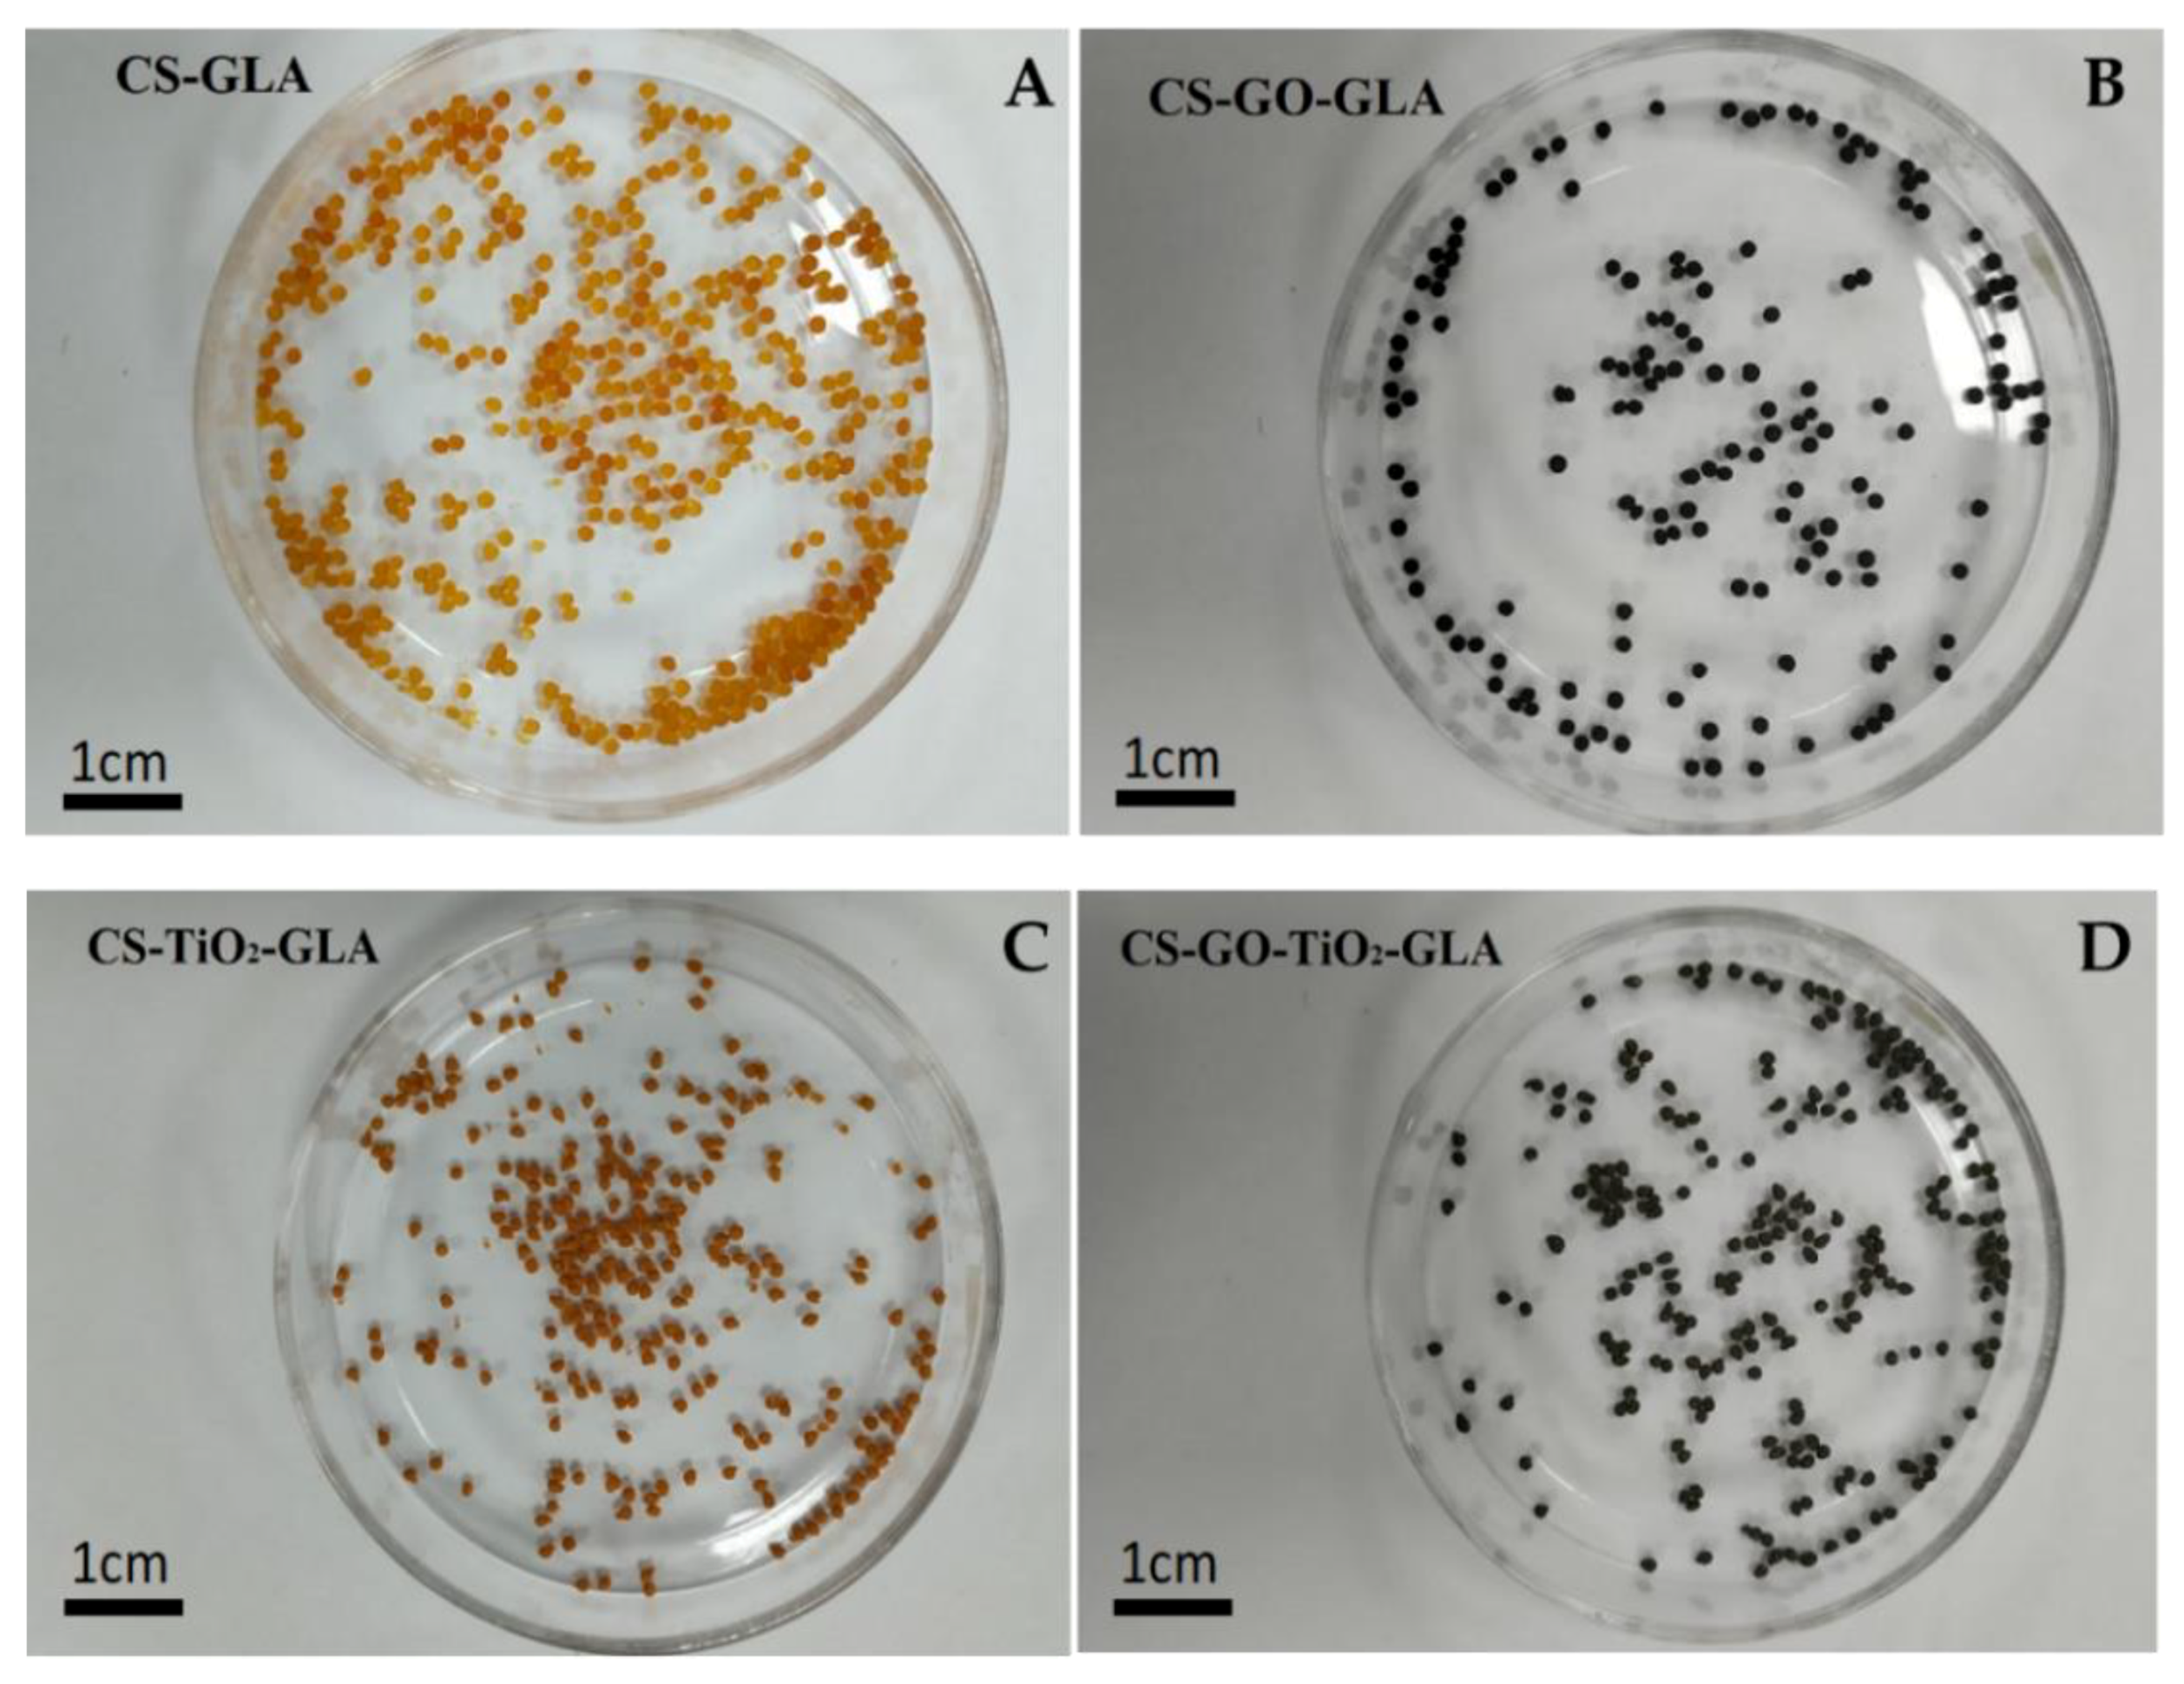
Molecules 25 02308 g006 Molecules 25 02308 g006

Synthesis of Chitosan Beads Incorporating Graphene Oxide/Titanium Dioxide Nanoparticles for In Vivo Studies
Abstract
1. Introduction
2. Results and Discussion
2.1. Characterization of Spherical Titanium Oxide Nanoparticles
2.2. GO Characterization
2.3. Bead Characterization
2.3.1. Fourier Transform Infrared Spectroscopy (FTIR)
2.3.2. X-ray Diffraction (DRX)
2.3.3. Scanning Electron Microscopy (SEM)
2.3.4. Thermogravimetric Analysis (TGA) and Differential Scanning Calorimetry (DSC) Analysis
2.3.5. TEM Images of the Nanocomposite Beads
2.3.6. In Vivo Biomodel Tests
2.4. Analysis of Porosity Results
3. Materials and Methods
3.1. Synthesis of TiO2 Nanoparticles
Characterization of TiO2 Nanoparticles
3.2. Preparation of Graphene Oxide (GO)
Characterization of Graphene Oxide (GO)
3.3. Synthesis of CS Nanocomposite Beads
Nanocomposite Beads Characterization
3.4. In Vivo Biomodel Tests
3.5. Statistical Analysis
4. Conclusions
Supplementary Materials
Author Contributions
Funding
Acknowledgments
Conflicts of Interest
References
- Khorshidi, S.; Solouk, A.; Mirzadeh, H.; Mazinani, S.; Lagaron, J.M.; Sharifi, S.; Ramakrishna, S. A review of key challenges of electrospun scaffolds for tissue-engineering applications. J. Tissue Eng. Regen. Med. 2016, 10, 715–738. [Google Scholar] [CrossRef] [PubMed]
- Gomes, M.E.; Azevedo, H.S.; Moreira, A.R.; Ellä, V.; Kellomäki, M.; Reis, R.L. Starch-poly (ε-caprolactone) and starch-poly (lactic acid) fibre-mesh scaffolds for bone tissue engineering applications: Structure, mechanical properties and degradation behaviour. J. Tissue Eng. Regen. Med. 2008, 2, 243–252. [Google Scholar] [CrossRef] [PubMed]
- Hollister, S.J. Porous scaffold design for tissue engineering. Nat. Mater. 2005, 4, 518–524. [Google Scholar] [CrossRef] [PubMed]
- Antunes, J.C.; Oliveira, J.M.; Reis, R.L.; Soria, J.M.; Gómez--Ribelles, J.L.; Mano, J.F. Novel poly (L-lactic acid)/hyaluronic acid macroporous hybrid scaffolds: Characterization and assessment of cytotoxicity. J. Biomed. Mater. Res. Part A 2010, 94, 856–869. [Google Scholar] [CrossRef]
- Stratton, S.; Shelke, N.B.; Hoshino, K.; Rudraiah, S.; Kumbar, S.G. Bioactive polymeric scaffolds for tissue engineering. Bioact. Mater. 2016, 1, 93–108. [Google Scholar] [CrossRef]
- Dhandayuthapani, B.; Yoshida, Y.; Maekawa, T.; Kumar, D.S. Polymeric scaffolds in tissue engineering application: A review. Int. J. Polym. Sci. 2011, 2011, 290602. [Google Scholar] [CrossRef]
- Muzzarelli, A.A.R.; Mehtedi, E.M.; Mattioli-Belmonte, M. Emerging Biomedical Applications of Nano-Chitins and Nano-Chitosans Obtained via Advanced Eco-Friendly Technologies from Marine Resources. Mar. Drugs 2014, 12, 5468–5502. [Google Scholar] [CrossRef]
- Seol, Y.-J.; Lee, J.-Y.; Park, Y.-J.; Lee, Y.-M.; Rhyu, I.-C.; Lee, S.-J.; Han, S.-B.; Chung, C.-P. Chitosan sponges as tissue engineering scaffolds for bone formation. Biotechnol. Lett. 2004, 26, 1037–1041. [Google Scholar] [CrossRef]
- Şenel, S.; McClure, S.J. Potential applications of chitosan in veterinary medicine. Adv. Drug Deliv. Rev. 2004, 56, 1467–1480. [Google Scholar] [CrossRef]
- Di Martino, A.; Sittinger, M.; Risbud, M.V. Chitosan: A versatile biopolymer for orthopaedic tissue-engineering. Biomaterials 2005, 26, 5983–5990. [Google Scholar] [CrossRef]
- Aranaz, I.; Mengíbar, M.; Harris, R.; Paños, I.; Miralles, B.; Acosta, N.; Galed, G.; Heras, Á. Functional characterization of chitin and chitosan. Curr. Chem. Biol. 2009, 3, 203–230. [Google Scholar]
- Archana, D.; Dutta, J.; Dutta, P.K. Evaluation of chitosan nano dressing for wound healing: Characterization, in vitro and in vivo studies. Int. J. Biol. Macromol. 2013, 57, 193–203. [Google Scholar] [CrossRef] [PubMed]
- Bui, V.K.H.; Park, D.; Lee, Y.-C. Chitosan combined with ZnO, TiO2 and Ag nanoparticles for antimicrobial wound healing applications: A mini review of the research trends. Polymers 2017, 9, 21. [Google Scholar] [CrossRef] [PubMed]
- Rizeq, B.R.; Younes, N.N.; Rasool, K.; Nasrallah, G.K. Synthesis, Bioapplications, and Toxicity Evaluation of Chitosan-Based Nanoparticles. Int. J. Mol. Sci. 2019, 20, 5776. [Google Scholar] [CrossRef]
- Mansoori, G.A. Principles of Nanotechnology: Molecular-Based Study of Condensed Matter in Small Systems; World Scientific Publishing Company: Hackensack, NJ, USA, 2005; p. 280. [Google Scholar]
- Saji, V.S.; Choe, H.C.; Yeung, K.W.K. Nanotechnology in biomedical applications: A review. Int. J. Nano Biomater. 2010, 3, 119–139. [Google Scholar] [CrossRef]
- Tamayo Marín, A.J.; Londoño, R.S.; Delgado, J.; Navia Porras, P.D.; Valencia Zapata, E.M.; Mina Hernandez, H.J.; Valencia, H.C.; Grande Tovar, D.C. Biocompatible and Antimicrobial Electrospun Membranes Based on Nanocomposites of Chitosan/Poly (Vinyl Alcohol)/Graphene Oxide. Int. J. Mol. Sci. 2019, 20, 2987. [Google Scholar] [CrossRef]
- López Tenorio, D.; Valencia, H.C.; Valencia, C.; Zuluaga, F.; Valencia, E.M.; Mina, H.J.; Grande Tovar, D.C. Evaluation of the Biocompatibility of CS-Graphene Oxide Compounds In Vivo. Int. J. Mol. Sci. 2019, 20, 1572. [Google Scholar] [CrossRef]
- Grande Tovar, C.D.; Castro, J.I.; Valencia, C.H.; Navia Porras, D.P.; Hernandez, M.; Herminsul, J.; Valencia, M.E.; Velásquez, J.D.; Chaur, M.N. Preparation of Chitosan/Poly (Vinyl Alcohol) Nanocomposite Films Incorporated with Oxidized Carbon Nano-Onions (Multi-Layer Fullerenes) for Tissue-Engineering Applications. Biomolecules 2019, 9, 684. [Google Scholar] [CrossRef]
- Alireza, K.; Ali, M.G. Nanostructured Titanium Dioxide Materials: Properties, Preparation and Applications; World scientific: Hackensack, NJ, USA, 2011; ISBN 9814397172. [Google Scholar]
- Gerhardt, L.-C.; Jell, G.M.R.; Boccaccini, A.R. Titanium dioxide (TiO2) nanoparticles filled poly (D, L lactid acid)(PDLLA) matrix composites for bone tissue engineering. J. Mater. Sci. Mater. Med. 2007, 18, 1287–1298. [Google Scholar] [CrossRef]
- Marszewski, M.; Jaroniec, M. Scaffold-assisted synthesis of crystalline mesoporous titania materials. RSC Adv. 2015, 5, 61960–61972. [Google Scholar] [CrossRef]
- Yin, Z.F.; Wu, L.; Yang, H.G.; Su, Y.H. Recent progress in biomedical applications of titanium dioxide. Phys. Chem. Chem. Phys. 2013, 15, 4844–4858. [Google Scholar] [CrossRef]
- Feng, B.; Weng, J.; Yang, B.C.; Qu, S.X.; Zhang, X.D. Characterization of surface oxide films on titanium and adhesion of osteoblast. Biomaterials 2003, 24, 4663–4670. [Google Scholar] [CrossRef]
- Hanawa, T. A comprehensive review of techniques for biofunctionalization of titanium. J. Periodontal Implant. Sci. 2011, 41, 263–272. [Google Scholar] [CrossRef] [PubMed]
- Mousavi, S.M.; Hashemi, S.A.; Ghasemi, Y.; Amani, A.M.; Babapoor, A.; Arjmand, O. Applications of graphene oxide in case of nanomedicines and nanocarriers for biomolecules: Review study. Drug Metab. Rev. 2019, 51, 12–41. [Google Scholar] [CrossRef] [PubMed]
- Kuila, T.; Bose, S.; Mishra, A.K.; Khanra, P.; Kim, N.H.; Lee, J.H. Chemical functionalization of graphene and its applications. Prog. Mater. Sci. 2012, 57, 1061–1105. [Google Scholar] [CrossRef]
- Song, Y.; Wei, W.; Qu, X. Colorimetric biosensing using smart materials. Adv. Mater. 2011, 23, 4215–4236. [Google Scholar] [CrossRef]
- Tao, Y.; Lin, Y.; Huang, Z.; Ren, J.; Qu, X. Incorporating graphene oxide and gold nanoclusters: A synergistic catalyst with surprisingly high peroxidase--like activity over a broad pH range and its application for cancer cell detection. Adv. Mater. 2013, 25, 2594–2599. [Google Scholar] [CrossRef]
- Mohanty, N.; Berry, V. Graphene-based single-bacterium resolution biodevice and DNA transistor: Interfacing graphene derivatives with nanoscale and microscale biocomponents. Nano Lett. 2008, 8, 4469–4476. [Google Scholar] [CrossRef]
- Kelly, K.F.; Billups, W.E. Synthesis of soluble graphite and graphene. Acc. Chem. Res. 2012, 46, 4–13. [Google Scholar] [CrossRef]
- Liu, X.; Ma, R.; Wang, X.; Ma, Y.; Yang, Y.; Zhuang, L.; Zhang, S.; Jehan, R.; Chen, J.; Wang, X. Graphene oxide-based materials for efficient removal of heavy metal ions from aqueous solution: A review. Environ. Pollut. 2019, 252, 62–73. [Google Scholar] [CrossRef] [PubMed]
- Valencia, C.; Valencia, C.; Zuluaga, F.; Valencia, M.; Mina, J.; Grande-Tovar, C. Synthesis and Application of Scaffolds of Chitosan-Graphene Oxide by the Freeze-Drying Method for Tissue Regeneration. Molecules 2018, 23, 2651. [Google Scholar] [CrossRef] [PubMed]
- Suk, J.W.; Piner, R.D.; An, J.; Ruoff, R.S. Mechanical properties of monolayer graphene oxide. ACS Nano 2010, 4, 6557–6564. [Google Scholar] [CrossRef] [PubMed]
- Li, D.; Müller, M.B.; Gilje, S.; Kaner, R.B.; Wallace, G.G. Processable aqueous dispersions of graphene nanosheets. Nat. Nanotechnol. 2008, 3, 101–105. [Google Scholar] [CrossRef] [PubMed]
- Sanchez, V.C.; Jachak, A.; Hurt, R.H.; Kane, A.B. Biological interactions of graphene-family nanomaterials: An interdisciplinary review. Chem. Res. Toxicol 2012, 25, 15–34. [Google Scholar] [CrossRef]
- Kiew, S.F.; Kiew, L.V.; Lee, H.B.; Imae, T.; Chung, L.Y. Assessing biocompatibility of graphene oxide-based nanocarriers: A review. J. Control. Release 2016, 226, 217–228. [Google Scholar] [CrossRef]
- Pan, Y.; Sahoo, N.G.; Li, L. The application of graphene oxide in drug delivery. Expert Opin. Drug Deliv. 2012, 9, 1365–1376. [Google Scholar] [CrossRef]
- Ji, H.; Sun, H.; Qu, X. Antibacterial applications of graphene-based nanomaterials: Recent achievements and challenges. Adv. Drug Deliv. Rev. 2016, 105, 176–189. [Google Scholar] [CrossRef]
- Xu, Y.; Zeng, J.; Chen, W.; Jin, R.; Li, B.; Pan, Z. A holistic review of cement composites reinforced with graphene oxide. Constr. Build. Mater. 2018, 171, 291–302. [Google Scholar] [CrossRef]
- Li, Y.; Wu, Q.; Zhao, Y.; Bai, Y.; Chen, P.; Xia, T.; Wang, D. Response of microRNAs to in vitro treatment with graphene oxide. ACS Nano 2014, 8, 2100–2110. [Google Scholar] [CrossRef]
- Liao, K.-H.; Lin, Y.-S.; Macosko, C.W.; Haynes, C.L. Cytotoxicity of graphene oxide and graphene in human erythrocytes and skin fibroblasts. ACS Appl. Mater. Interfaces 2011, 3, 2607–2615. [Google Scholar] [CrossRef]
- Chang, Y.; Yang, S.-T.; Liu, J.-H.; Dong, E.; Wang, Y.; Cao, A.; Liu, Y.; Wang, H. In vitro toxicity evaluation of graphene oxide on A549 cells. Toxicol. Lett. 2011, 200, 201–210. [Google Scholar] [CrossRef] [PubMed]
- Sharma, C.; Dinda, A.K.; Potdar, P.D.; Chou, C.-F.; Mishra, N.C. Fabrication and characterization of novel nano-biocomposite scaffold of chitosan-gelatin-alginate-hydroxyapatite for bone tissue engineering. Mater. Sci. Eng. C 2016, 64, 416–427. [Google Scholar] [CrossRef] [PubMed]
- Durkut, S.; Elçin, Y.M.; Elçin, A.E. Biodegradation of chitosan-tripolyphosphate beads: In vitro and in vivo studies. Artif. Cells Blood Sub. 2006, 34, 263–276. [Google Scholar] [CrossRef] [PubMed]
- Jayakumar, R.; Menon, D.; Manzoor, K.; Nair, S.V.; Tamura, H. Biomedical applications of chitin and chitosan based nanomaterials—A short review. Carbohydr. Polym. 2010, 82, 227–232. [Google Scholar] [CrossRef]
- Lim, S.M.; Song, D.K.; Oh, S.H.; Lee-Yoon, D.S.; Bae, E.H.; Lee, J.H. In vitro and in vivo degradation behavior of acetylated chitosan porous beads. J. Biomater. Sci. Polym. Ed. 2008, 19, 453–466. [Google Scholar] [CrossRef]
- Kim, S.E.; Park, J.H.; Cho, Y.W.; Chung, H.; Jeong, S.Y.; Lee, E.B.; Kwon, I.C. Porous chitosan scaffold containing microspheres loaded with transforming growth factor-β1: Implications for cartilage tissue engineering. J. Control. Release 2003, 91, 365–374. [Google Scholar] [CrossRef]
- Kravanja, G.; Primožič, M.; Knez, Ž.; Leitgeb, M. Chitosan-Based (Nano)Materials for Novel Biomedical Applications. Molecules 2019, 24, 1960. [Google Scholar] [CrossRef]
- Mohandas, A.; Deepthi, S.; Biswas, R.; Jayakumar, R. Chitosan based metallic nanocomposite scaffolds as antimicrobial wound dressings. Bioact. Mater. 2018, 3, 267–277. [Google Scholar] [CrossRef]
- Zapata, P.A.; Palza, H.; Delgado, K.; Rabagliati, F.M. Novel antimicrobial polyethylene composites prepared by metallocenic in situ polymerization with TiO2--based nanoparticles. J. Polym. Sci. Part A Polym. Chem. 2012, 50, 4055–4062. [Google Scholar] [CrossRef]
- Bartelmess, J.; Giordani, S. Carbon nano-onions (multi-layer fullerenes): Chemistry and applications. Beilstein J. Nanotechnol. 2014, 5, 1980–1998. [Google Scholar] [CrossRef]
- Gholampour, A.; Valizadeh Kiamahalleh, M.; Tran, D.N.H.; Ozbakkaloglu, T.; Losic, D. From Graphene Oxide to Reduced Graphene Oxide: Impact on the Physiochemical and Mechanical Properties of Graphene-Cement Composites. ACS Appl. Mater. Interfaces 2017, 9, 43275–43286. [Google Scholar] [CrossRef] [PubMed]
- Sánchez-Valdes, S.; Zapata-Domínguez, A.G.; Martinez-Colunga, J.G.; Mendez-Nonell, J.; Ramos de Valle, L.F.; Espinoza-Martinez, A.B.; Morales-Cepeda, A.; Lozano-Ramirez, T.; Lafleur, P.G.; Ramirez-Vargas, E. Influence of functionalized polypropylene on polypropylene/graphene oxide nanocomposite properties. Polym. Compos. 2018, 39, 1361–1369. [Google Scholar] [CrossRef]
- Ruiz, S.; Tamayo, A.J.; Delgado Ospina, J.; Navia Porras, P.D.; Valencia Zapata, E.M.; Mina Hernandez, H.J.; Valencia, H.C.; Zuluaga, F.; Grande Tovar, D.C. Antimicrobial Films Based on Nanocomposites of Chitosan/Poly(vinyl alcohol)/Graphene Oxide for Biomedical Applications. Biomolecules 2019, 9, 109. [Google Scholar] [CrossRef] [PubMed]
- Kulkarni, V.H.; Kulkarni, P.V.; Keshavayya, J. Glutaraldehyde--crosslinked chitosan beads for controlled release of diclofenac sodium. J. Appl. Polym. Sci. 2007, 103, 211–217. [Google Scholar] [CrossRef]
- Ngah, W.S.W.; Fatinathan, S. Adsorption of Cu (II) ions in aqueous solution using chitosan beads, chitosan–GLA beads and chitosan–alginate beads. Chem. Eng. J. 2008, 143, 62–72. [Google Scholar] [CrossRef]
- Monteiro, O.A.C., Jr.; Airoldi, C. Some studies of crosslinking chitosan–glutaraldehyde interaction in a homogeneous system. Int. J. Biol. Macromol. 1999, 26, 119–128. [Google Scholar] [CrossRef]
- Mallakpour, S.; Zadehnazari, A. A facile, efficient, and rapid covalent functionalization of multi-walled carbon nanotubes with natural amino acids under microwave irradiation. Prog. Org. Coatings 2014, 77, 679–684. [Google Scholar] [CrossRef]
- Feng, F.; Liu, Y.; Zhao, B.; Hu, K. Characterization of half N-acetylated chitosan powders and films. Procedia Eng. 2012, 27, 718–732. [Google Scholar] [CrossRef]
- Samuels, R.J. Solid state characterization of the structure of chitosan films. J. Polym. Sci. Polym. Phys. Ed. 1981, 19, 1081–1105. [Google Scholar] [CrossRef]
- Salmon, S.; Hudson, S.M. Crystal morphology, biosynthesis, and physical assembly of cellulose, chitin, and chitosan. J. Macromol. Sci. Part C Polym. Rev. 1997, 37, 199–276. [Google Scholar] [CrossRef]
- Goumri, M.; Poilâne, C.; Ruterana, P.; Doudou, B.B.; Wéry, J.; Bakour, A.; Baitoul, M. Synthesis and characterization of nanocomposites films with graphene oxide and reduced graphene oxide nanosheets. Chinese J. Phys. 2017, 55, 412–422. [Google Scholar] [CrossRef]
- Fu, G.; Vary, P.S.; Lin, C.-T. Anatase TiO2 nanocomposites for antimicrobial coatings. J. Phys. Chem. B 2005, 109, 8889–8898. [Google Scholar] [CrossRef] [PubMed]
- Amin, S.A.; Pazouki, M.; Hosseinnia, A. Synthesis of TiO2–Ag nanocomposite with sol-gel method and investigation of its antibacterial activity against E. coli. Powder Technol. 2009, 196, 241–245. [Google Scholar] [CrossRef]
- Khanna, P.K.; Singh, N.; Charan, S. Synthesis of nanoparticles of anatase-TiO2 and preparation of its optically transparent film in PVA. Mater. Lett. 2007, 61, 4725–4730. [Google Scholar] [CrossRef]
- Mahshid, S.; Askari, M.; Ghamsari, M.S. Synthesis of TiO2 nanoparticles by hydrolysis and peptization of titanium isopropoxide solution. J. Mater. Process. Technol. 2007, 189, 296–300. [Google Scholar] [CrossRef]
- Sangeetha, K.; Angelin Vinodhini, P.; Sudha, P.N.; Alsharani Faleh, A.; Sukumaran, A. Novel chitosan based thin sheet nanofiltration membrane for rejection of heavy metal chromium. Int. J. Biol. Macromol. 2019, 132, 939–953. [Google Scholar]
- Tang, C.; Chen, N.; Zhang, Q.; Wang, K.; Fu, Q.; Zhang, X. Preparation and properties of chitosan nanocomposites with nanofillers of different dimensions. Polym. Degrad. Stab. 2009, 94, 124–131. [Google Scholar] [CrossRef]
- Pandele, A.M.; Ionita, M.; Crica, L.; Dinescu, S.; Costache, M.; Iovu, H. Synthesis, characterization, and in vitro studies of graphene oxide/chitosan-polyvinyl alcohol films. Carbohydr. Polym. 2014, 102, 813–820. [Google Scholar] [CrossRef]
- Yang, X.; Tu, Y.; Li, L.; Shang, S.; Tao, X. Well-Dispersed Chitosan/Graphene Oxide Nanocomposites. ACS Appl. Mater. Interfaces 2010, 2, 1707–1713. [Google Scholar] [CrossRef]
- Celebi, H.; Kurt, A. Effects of processing on the properties of chitosan/cellulose nanocrystal films. Carbohydr. Polym. 2015, 133, 284–293. [Google Scholar] [CrossRef]
- Monier, M.; Ayad, D.M.; Wei, Y.; Sarhan, A.A. Immobilization of horseradish peroxidase on modified chitosan beads. Int. J. Biol. Macromol. 2010, 46, 324–330. [Google Scholar] [CrossRef] [PubMed]
- Ma, Q.; Liang, T.; Cao, L.; Wang, L. Intelligent poly (vinyl alcohol)-chitosan nanoparticles-mulberry extracts films capable of monitoring pH variations. Int. J. Biol. Macromol. 2018, 108, 576–584. [Google Scholar] [CrossRef]
- Yadav, I.; Nayak, S.K.; Rathnam, V.S.S.; Banerjee, I.; Ray, S.S.; Anis, A.; Pal, K. Reinforcing effect of graphene oxide reinforcement on the properties of poly (vinyl alcohol) and carboxymethyl tamarind gum based phase-separated film. J. Mech. Behav. Biomed. Mater. 2018, 81, 61–71. [Google Scholar] [CrossRef] [PubMed]
- Li, S.; Pan, X.; Wallis, L.K.; Fan, Z.; Chen, Z.; Diamond, S.A. Comparison of TiO2 nanoparticle and graphene–TiO2 nanoparticle composite phototoxicity to Daphnia magna and Oryzias latipes. Chemosphere 2014, 112, 62–69. [Google Scholar] [CrossRef] [PubMed]
- Tomihata, K.; Ikada, Y. In vitro and in vivo degradation of films of chitin and its deacetylated derivatives. Biomaterials 1997, 18, 567–575. [Google Scholar] [CrossRef]
- Pella, M.C.G.; Lima-Tenório, M.K.; Tenorio-Neto, E.T.; Guilherme, M.R.; Muniz, E.C.; Rubira, A.F. Chitosan-based hydrogels: From preparation to biomedical applications. Carbohydr. Polym. 2018, 196, 233–245. [Google Scholar] [CrossRef]
- Fujita, M.; Ishihara, M.; Simizu, M.; Obara, K.; Ishizuka, T.; Saito, Y.; Yura, H.; Morimoto, Y.; Takase, B.; Matsui, T. Vascularization in vivo caused by the controlled release of fibroblast growth factor-2 from an injectable chitosan/non-anticoagulant heparin hydrogel. Biomaterials 2004, 25, 699–706. [Google Scholar] [CrossRef]
- Pawar, V.; Bulbake, U.; Khan, W.; Srivastava, R. Chitosan sponges as a sustained release carrier system for the prophylaxis of orthopedic implant-associated infections. Int. J. Biol. Macromol. 2019, 134, 100–112. [Google Scholar] [CrossRef]
- Rinaudo, M.; Milas, M.; Le Dung, P. Characterization of chitosan. Influence of ionic strength and degree of acetylation on chain expansion. Int. J. Biol. Macromol. 1993, 15, 281–285. [Google Scholar] [CrossRef]
- Mangadlao, J.D.; De Leon, A.C.C.; Felipe, M.J.L.; Cao, P.; Advincula, P.A.; Advincula, R.C. Grafted carbazole-assisted electrodeposition of graphene oxide. ACS Appl. Mater. Interfaces 2015, 7, 10266–10274. [Google Scholar] [CrossRef]
- Fan, J.; Grande, C.D.; Rodrigues, D.F. Biodegradation of graphene oxide-polymer nanocomposite films in wastewater. Environ. Sci. Nano 2017, 4, 1808–1816. [Google Scholar] [CrossRef]
- Grande, C.D.; Mangadlao, J.; Fan, J.; De Leon, A.; Delgado-Ospina, J.; Rojas, J.G.; Rodrigues, D.F.; Advincula, R. Chitosan Cross-Linked Graphene Oxide Nanocomposite Films with Antimicrobial Activity for Application in Food Industry. Macromol. Symp. 2017, 374, 1600114. [Google Scholar] [CrossRef]
- Valencia Zapata, E.M.; Mina Hernandez, H.J.; Grande Tovar, D.C.; Valencia Llano, H.C.; Diaz Escobar, A.J.; Vázquez-Lasa, B.; San Román, J.; Rojo, L. Novel Bioactive and Antibacterial Acrylic Bone Cement Nanocomposites Modified with Graphene Oxide and Chitosan. Int. J. Mol. Sci. 2019, 20, 2938. [Google Scholar] [CrossRef] [PubMed]
- Zhao, F.; Yu, B.; Yue, Z.; Wang, T.; Wen, X.; Liu, Z.; Zhao, C. Preparation of porous chitosan gel beads for copper ( II ) ion adsorption. J. Hazard. Mater. 2007, 147, 67–73. [Google Scholar] [CrossRef]
- Jeon, C.; Wolfgang, H.H. Chemical modification of chitosan and equilibrium study for mercury ion removal. Water Res. 2003, 37, 4770–4780. [Google Scholar] [CrossRef]
- Nara, S.; Komiya, T. Studies on the Relationship Between Water-satured State and Crystallinity by the Diffraction Method for Moistened Potato Starch. Starke 1983, 35, 407–410. [Google Scholar] [CrossRef]
Sample Availability: Samples of the compounds of the different nanocomposite beads: (A) CS-GLA, (B) CS-GO-GLA, (C) CS-TiO2-GLA, and (D) CS-TiO2-GO-GLA are available from the authors. |

| Formulation | Xc (%) |
|---|---|
| CS-GLA | 10.8 |
| CS-GO-GLA | 15.5 |
| CS-TiO2-GLA | 24.0 |
| CS-TiO2-GO-GLA | 21.8 |
| Sample | Td3% (°C) |
|---|---|
| CS-GLA | 92.8 |
| CS-GO-GLA | 131.3 |
| CS-TiO2-GLA | 85.8 |
| CS-TiO2-GO-GLA | 124.7 |
| CS pure | 44.2 |
© 2020 by the authors. Licensee MDPI, Basel, Switzerland. This article is an open access article distributed under the terms and conditions of the Creative Commons Attribution (CC BY) license (http://creativecommons.org/licenses/by/4.0/).
Share and Cite
Grande Tovar, C.D.; Castro, J.I.; Valencia, C.H.; Zapata, P.A.; Solano, M.A.; Florez López, E.; Chaur, M.N.; Valencia Zapata, M.E.; Mina Hernandez, J.H. Synthesis of Chitosan Beads Incorporating Graphene Oxide/Titanium Dioxide Nanoparticles for In Vivo Studies. Molecules 2020, 25, 2308. https://doi.org/10.3390/molecules25102308
Grande Tovar CD, Castro JI, Valencia CH, Zapata PA, Solano MA, Florez López E, Chaur MN, Valencia Zapata ME, Mina Hernandez JH. Synthesis of Chitosan Beads Incorporating Graphene Oxide/Titanium Dioxide Nanoparticles for In Vivo Studies. Molecules. 2020; 25(10):2308. https://doi.org/10.3390/molecules25102308
Chicago/Turabian StyleGrande Tovar, Carlos David, Jorge Iván Castro, Carlos Humberto Valencia, Paula A. Zapata, Moisés A. Solano, Edwin Florez López, Manuel N. Chaur, Mayra Eliana Valencia Zapata, and José Herminsul Mina Hernandez. 2020. "Synthesis of Chitosan Beads Incorporating Graphene Oxide/Titanium Dioxide Nanoparticles for In Vivo Studies" Molecules 25, no. 10: 2308. https://doi.org/10.3390/molecules25102308
APA StyleGrande Tovar, C. D., Castro, J. I., Valencia, C. H., Zapata, P. A., Solano, M. A., Florez López, E., Chaur, M. N., Valencia Zapata, M. E., & Mina Hernandez, J. H. (2020). Synthesis of Chitosan Beads Incorporating Graphene Oxide/Titanium Dioxide Nanoparticles for In Vivo Studies. Molecules, 25(10), 2308. https://doi.org/10.3390/molecules25102308

